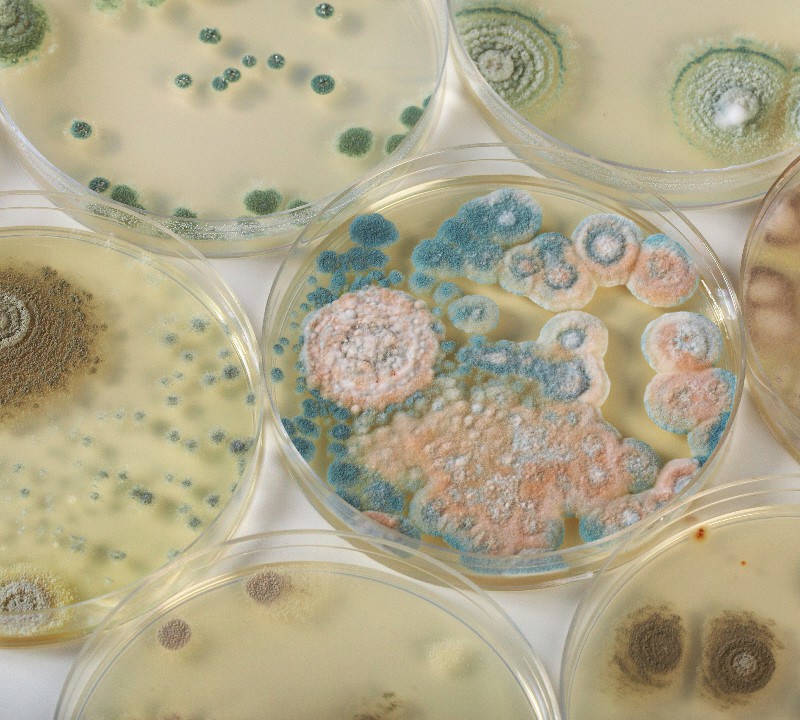

Bacteria
Bacteria are the oldest living organisms on earth. There is hardly a place on earth that is not densely colonized with bacteria.
More bacteria live on and in the human body than the human body has cells. Without their bacteria, they would be 3 kg lighter, but no longer viable.
What we usually call „bacteria“ (the prokaryotes) consists of two groups, the archaea and the „real“ bacteria.
Bacteria do not have sex, bacteria reproduce by division. There is sometimes a certain gene transfer from bacterium to bacterium via bacterial penises, the so-called bacterial conjugation. However, this is not gene-mixing sex, but a virus-like gene transfer.
More about bacteria and bacterial conjugation in the chapter: „Our first sex When? With whom? Was it nice?“
zurück